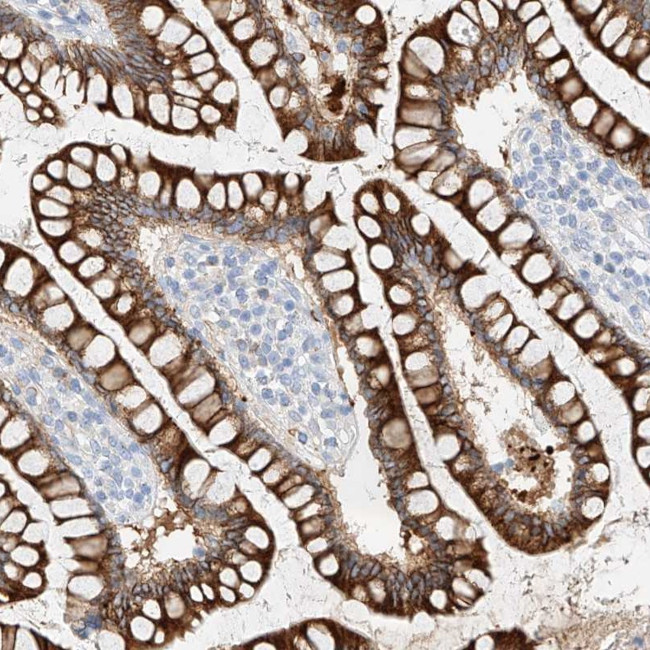
MAP7 Antibody in Immunohistochemistry (Paraffin) (IHC (P))

Search
Invitrogen
MAP7 Polyclonal Antibody
{{$productOrderCtrl.translations['antibody.pdp.commerceCard.promotion.promotions']}}
{{$productOrderCtrl.translations['antibody.pdp.commerceCard.promotion.viewpromo']}}
{{$productOrderCtrl.translations['antibody.pdp.commerceCard.promotion.promocode']}}: {{promo.promoCode}} {{promo.promoTitle}} {{promo.promoDescription}}. {{$productOrderCtrl.translations['antibody.pdp.commerceCard.promotion.learnmore']}}
产品信息
PA5-56235
种属反应
宿主/亚型
分类
类型
抗原
偶联物
形式
浓度
规格
纯化类型
保存液
内含物
保存条件
运输条件
RRID
产品详细信息
Immunogen sequence: PHLPGTPRPT SSLPPGSVKA APAQVRPPSP GNIRPVKREV KVEPEKKDPE KEPQKVANEP SLKGRAPLVK VEEATVEERT PAEPEVGPAA P
Highest antigen sequence identity to the following orthologs: Mouse - 69%, Rat - 70%.
靶标信息
The product of this gene is a microtubule-associated protein that is predominantly expressed in cells of epithelial origin. Microtubule-associated proteins are thought to be involved in microtubule dynamics, which is essential for cell polarization and differentiation. This protein has been shown to be able to stabilize microtubules, and may serve to modulate microtubule functions. Studies of the related mouse protein also suggested an essential role in microtubule function required for spermatogenesis. Multiple alternatively spliced transcript variants encoding different isoforms have been found for this gene.
仅用于科研。不用于诊断过程。未经明确授权不得转售。
篇参考文献 (0)
生物信息学
蛋白别名: dJ325F22.2 (microtubule-associated protein 7 (EMAP115, E-MAP-115)); E-MAP-115; Ensconsin; Epithelial microtubule-associated protein of 115 kDa; MAP-7; Microtubule-associated protein 7; unnamed protein product
基因别名: E-MAP-115; EMAP115; MAP7
UniProt ID: (Human) Q14244
Entrez Gene ID: (Human) 9053